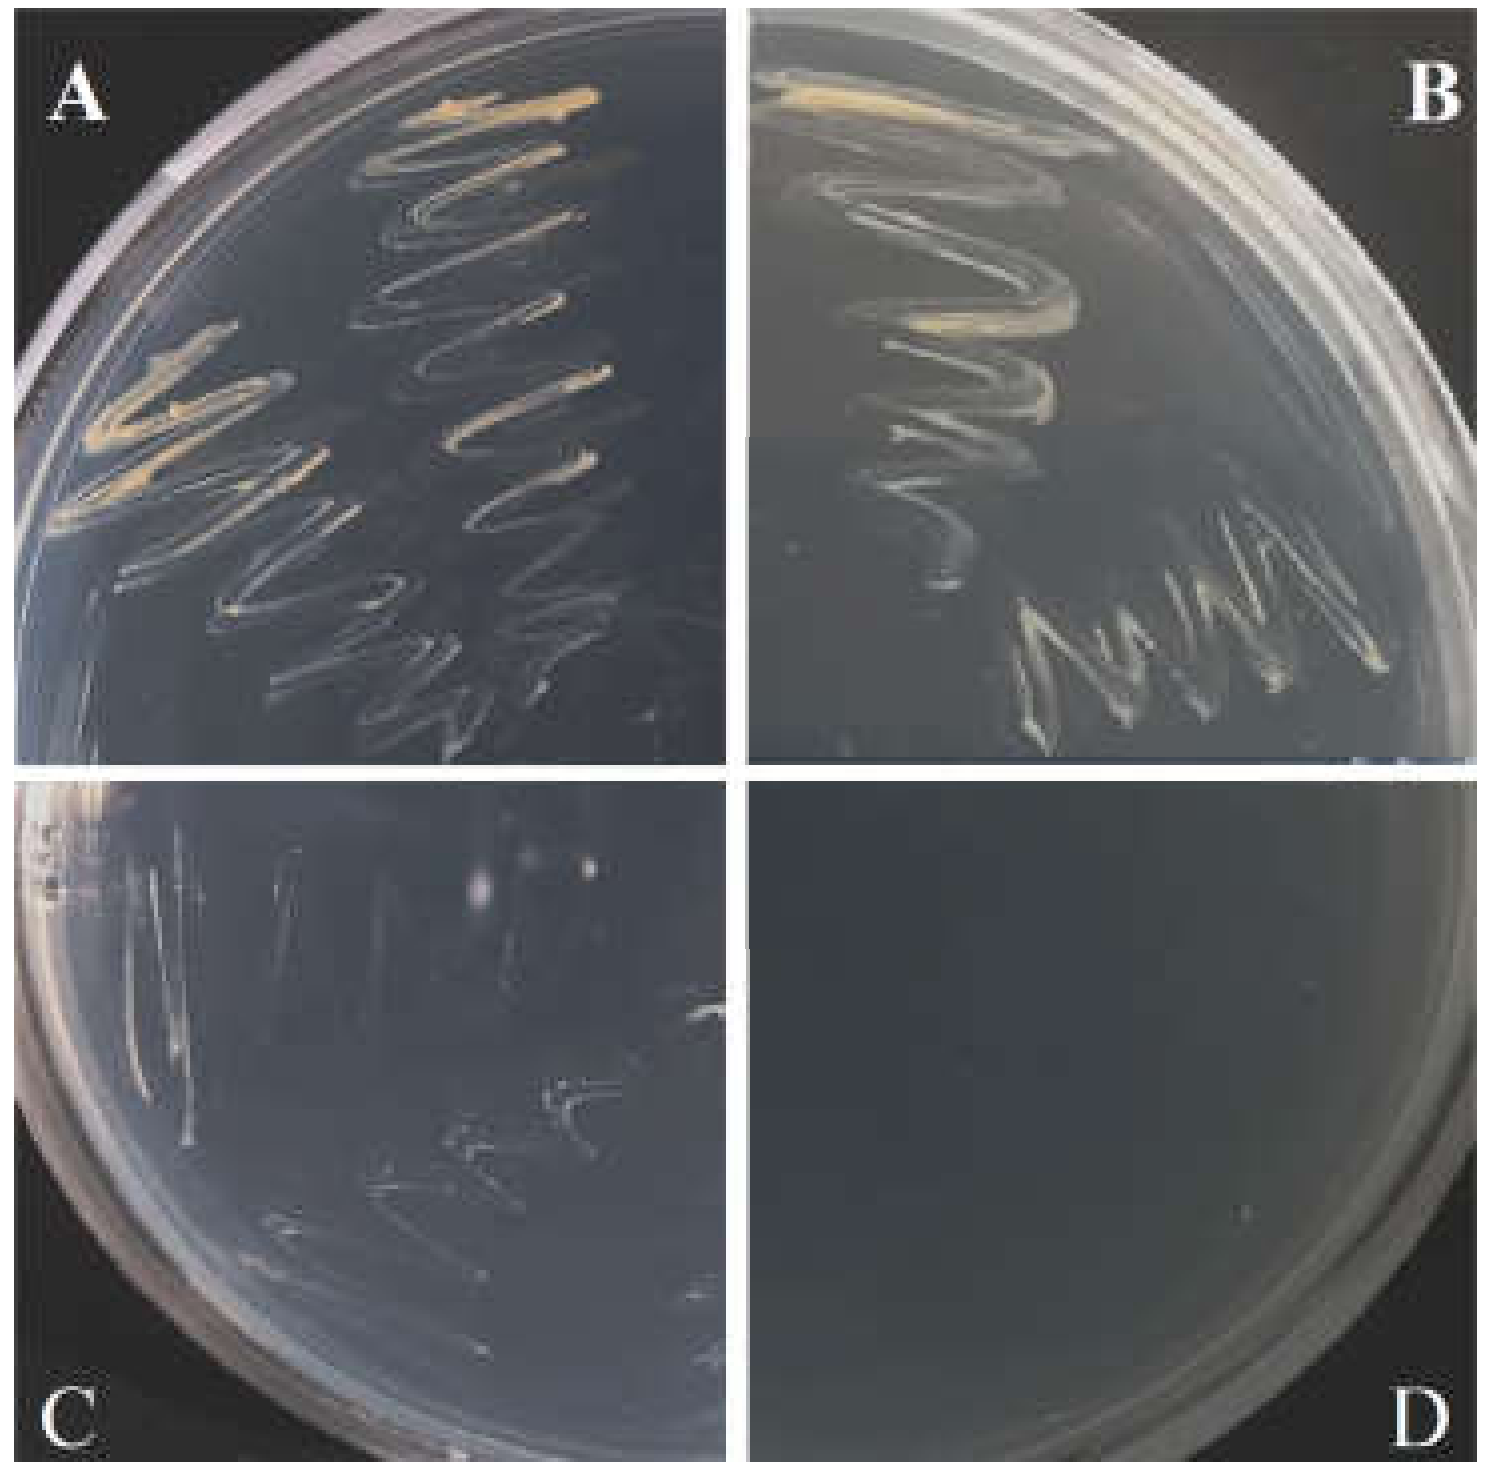

Enduring Effect of Antibiotic Timentin Treatment on Tobacco In Vitro Shoot Growth and Microbiome Diversity
Abstract
1. Introduction
2. Results
2.1. Effect of Antibiotic on Tobacco Shoot Growth and Oxidative Stress Injury
2.2. Analysis of Bacterial Diversity in Tobacco In Vitro Shoot Samples
2.3. Antibiotic Effect on Bacterial Diversity in Tobacco Shoot Culture
2.4. Isolation of Actinobacteria and Antibiotic Resistance Assessment
3. Discussion
4. Materials and Methods
4.1. Tobacco Shoot Culture In Vitro and Antibiotic Treatment
4.2. Assessment of Oxidative Stress Injury
4.3. 16S rRNA Gene Sequencing-Based Microbiome Analysis
4.4. Mycobacterium Isolation, Identification, and Antibiotic Resistance Test
4.5. Statistical Data Analysis
5. Conclusions
Supplementary Materials
Author Contributions
Funding
Institutional Review Board Statement
Informed Consent Statement
Data Availability Statement
Acknowledgments
Conflicts of Interest
Appendix A
| Time, Days | TC | TA | PA |
|---|---|---|---|
| Fresh weight, mg | |||
| 21 | 164.7 ± 3.3 | 116.8 ± 6.3 ** | 148.9 ± 4.6 * |
| MDA concentration, nmol·g−1 FW | |||
| 4 | 95.6 ± 2.6 | 116.5 ± 3.1 ** | 105.8 ± 2.9 * |
| 7 | 71.2 ± 1.8 | 110.9 ± 2.6 ** | 95.2 ± 2.5 ** |
| 14 | 81.8 ± 1.8 | 110.4 ± 2.7 ** | 98.4 ± 3.3 ** |
| 21 | 89.0 ± 2.8 | 118.0 ± 2.5 ** | 98.7 ± 1.7 * |
| Index | TC/PA | |||||
|---|---|---|---|---|---|---|
| V2 | V3 | V4 | V6–7 | V8 | Consensus | |
| Mean read length | 225/224 | 225/224 | 225/224 | 225/224 | 225/224 | 225/224 |
| Number of valid reads | 116,092/ 132,515 | 349,444/ 377,876 | 181,248/ 146,578 | 185,318/ 213,622 | 404,496/ 465,096 | 1,236,598/ 1,335,687 |
| Number of mapped reads | 97,960/ 112,951 | 292,732/ 337,581 | 135,486/ 119,123 | 158,876/ 189,120 | 342,522/ 417,163 | 423,470/ 713,037 |
| Number of reads mapped to bacterial OTUs | 18,510/ 11,867 | 9454/ 1363 | 114,912/ 82,749 | 52,866/ 34,291 | 127,428/ 74,804 | 323,170/ 205,074 |
| Number of OTUs | 27/3 | 45/4 | 62/10 | 42/5 | 69/12 | 245/34 |
References
- Brader, G.; Compant, S.; Vescio, K.; Mitter, B.; Trognitz, F.; Ma, L.-J.; Sessitsch, A. Ecology and genomic insights into plant-pathogenic and plant-nonpathogenic endophytes. Annu. Rev. Phytopathol. 2017, 55, 61–83. [Google Scholar] [CrossRef] [PubMed]
- Kukkurainen, S.; Leino, A.; Vaähaämiko, S.; Kaärkkaäinen, H.R.; Ahanen, K.; Sorvari, S.; Rugienius, R.; Toldi, O. Occurrence and location of endophytic bacteria in garden and wild strawberry. HortScience 2005, 40, 348–352. [Google Scholar] [CrossRef]
- Abreu-Tarazi, M.F.; Navarrete, A.A.; Andreote, F.D.; Almeida, C.V.; Tsai, S.M.; Almeida, M. Endophytic bacteria in long-term in vitro cultivated “axenic” pineapple microplants revealed by PCR–DGGE. World J. Microbiol. Biotechnol. 2010, 26, 555–560. [Google Scholar] [CrossRef]
- Leone, G.F.; Andrade, P.A.M.; de Almeida, C.V.; de Almeida, C.V.; Dini Andreote, F.; de Almeida, M. Use of antibiotics to control endophytic bacterial growth migration onto culture medium in Eucalyptus cloeziana F. Muell.: A micropropagation approach. In Vitro Cell. Dev. Biol. Plant 2019, 55, 421–432. [Google Scholar] [CrossRef]
- Botta, A.L.; Santacecilia, A.; Ercole, C.; Cacchio, P.; Del Gallo, M. In vitro and in vivo inoculation of four endophytic bacteria on Lycopersicon esculentum. New Biotechnol. 2013, 30, 666–674. [Google Scholar] [CrossRef]
- Salomon, M.V.; Bottini, R.; de Souza Filho, G.A.; Cohen, A.C.; Moreno, D.; Gil, M.; Piccoli, P. Bacteria isolated from roots and rhizosphere of Vitis vinifera retard water losses, induce abscisic acid accumulation and synthesis of defense-related terpenes in in vitro cultured grapevine. Physiol. Plant. 2014, 151, 359–374. [Google Scholar] [CrossRef]
- Quambusch, M.; Brümmer, J.; Haller, K.; Winkelmann, T.; Bartsch, M. Dynamics of endophytic bacteria in plant in vitro culture: Quantification of three bacterial strains in Prunus avium in different plant organs and in vitro culture phases. Plant Cell Tiss. Org. Cult. 2016, 126, 305–317. [Google Scholar] [CrossRef]
- Tamošiūnė, I.; Stanienė, G.; Haimi, P.; Stanys, V.; Rugienius, R.; Baniulis, D. Endophytic Bacillus and Pseudomonas spp. modulate apple shoot growth, cellular redox balance, and protein expression under in vitro conditions. Front. Plant Sci. 2018, 9, 889. [Google Scholar] [CrossRef]
- Maggini, V.; Mengoni, A.; Gallo, E.R.; Biffi, S.; Fani, R.; Firenzuoli, F.; Bogani, P. Tissue specificity and differential effects on in vitro plant growth of single bacterial endophytes isolated from the roots, leaves and rhizospheric soil of Echinacea purpurea. BMC Plant Biol. 2019, 19, 284. [Google Scholar] [CrossRef]
- Andriūnaitė, E.; Tamošiūnė, I.; Aleksandravičiūtė, M.; Gelvonauskienė, D.; Vinskienė, J.; Rugienius, R.; Baniulis, D. Stimulation of Nicotiana tabacum L. in vitro shoot growth by endophytic Bacillus cereus group bacteria. Microorganisms 2021, 9, 1893. [Google Scholar] [CrossRef]
- Cassells, A.C. Problems in Tissue Culture: Culture Contamination. In Micropropagation: Technology and Application; Debergh, P.C., Zimmerman, R.H., Eds.; Springer: Dordrecht, The Netherlands, 1991; pp. 31–44. [Google Scholar]
- Cassells, A.C.; Tahmatsidou, V. The influence of local plant growth conditions on non-fastidious bacterial contamination of meristem-tips of Hydrangea cultured in vitro. Plant Cell Tiss. Org. Cult. 1996, 47, 15–26. [Google Scholar] [CrossRef]
- Reed, B.M.; Buckley, P.M.; DeWilde, T.N. Detection and eradication of endophytic bacteria from micropropagated mint plants. In Vitro Cell. Dev. Biol. Plant 1995, 31, 53–57. [Google Scholar] [CrossRef]
- Kulkarni, A.A.; Kelkar, S.; Watve, M.; Krishnamurthy, K. Characterization and control of endophytic bacterial contaminants in in vitro cultures of Piper spp., Taxus baccata subsp. wallichiana, and Withania somnifera. Can. J. Microbiol. 2007, 53, 63–74. [Google Scholar] [CrossRef] [PubMed]
- Thomas, P. In vitro decline in plant cultures: Detection of a legion of covert bacteria as the cause for degeneration of long-term micropropagated triploid watermelon cultures. Plant Cell Tiss. Org. Cult. 2004, 77, 173–179. [Google Scholar] [CrossRef]
- Pirttilä, A.M.; Podolich, O.; Koskimäki, J.J.; Hohtola, E.; Hohtola, A. Role of origin and endophyte infection in browning of bud-derived tissue cultures of Scots pine (Pinus sylvestris L.). Plant Cell Tiss. Org. Cult. 2008, 95, 47–55. [Google Scholar] [CrossRef]
- Thomas, P.; Swarna, G.K.; Patil, P.; Rawal, R.D. Ubiquitous presence of normally non-culturable endophytic bacteria in field shoot-tips of banana and their gradual activation to quiescent cultivable form in tissue cultures. Plant Cell Tiss. Org. Cult. 2008, 93, 39–54. [Google Scholar] [CrossRef]
- Ray, S.S.; Ali, M.N.; Mukherjee, S.; Chatterjee, G.; Banerjee, M. Elimination and molecular identification of endophytic bacterial contaminants during in vitro propagation of Bambusa balcooa. World J. Microbiol. Biotechnol. 2017, 33, 1–9. [Google Scholar] [CrossRef]
- Wojtania, A.; PvBawska, J.; Gabryszewska, E. Identification and elimination of bacterial contaminants from Pelargonium tissue cultures. J. Fruit Ornam. Plant Res. 2005, 13, 101–108. [Google Scholar]
- Chen, W.L.; Yeh, D.M. Elimination of in vitro contamination, shoot multiplication, and ex vitro rooting of Aglaonema. HortScience 2007, 42, 629–632. [Google Scholar] [CrossRef]
- Anami, S.; Njuguna, E.; Coussens, G.; Aesaert, S.; Van Lijsebettens, M. Higher plant transformation: Principles and molecular tools. Int. J. Dev. Biol. 2013, 57, 483–494. [Google Scholar] [CrossRef]
- Breyer, D.; Kopertekh, L.; Reheul, D. Alternatives to antibiotic resistance marker genes for in vitro selection of genetically modified plants—Scientific developments, current use, operational access and biosafety considerations. Crit. Rev. Plant Sci. 2014, 33, 286–330. [Google Scholar] [CrossRef]
- Pu, X.-A.; Goodman, R.N. Induction of necrogenesis by Agrobacterium tumefaciens on grape explants. Physiol. Mol. Plant Pathol. 1992, 41, 241–254. [Google Scholar] [CrossRef]
- Deng, W.; Pu, X.A.; Goodman, R.N.; Gordon, M.P.; Nester, E.W. T-DNA genes responsible for inducing a necrotic response on grape vines. Mol. Plant-Microbe Interact. 1995, 8, 538–548. [Google Scholar] [CrossRef] [PubMed]
- Ozawa, K. Establishment of a high efficiency Agrobacterium-mediated transformation system of rice (Oryza sativa L.). Plant Sci. 2009, 176, 522–527. [Google Scholar] [CrossRef]
- Nauerby, B.; Billing, K.; Wyndaele, R. Influence of the antibiotic timentin on plant regeneration compared to carbenicillin and cefotaxime in concentrations suitable for elimination of Agrobacterium tumefaciens. Plant Sci. 1997, 123, 169–177. [Google Scholar] [CrossRef]
- Ogawa, Y.; Mii, M. Screening for highly active β-lactam antibiotics against Agrobacterium tumefaciens. Arch. Microbiol. 2004, 181, 331–336. [Google Scholar] [CrossRef]
- Priya, A.M.; Pandian, S.K.; Manikandan, R. The effect of different antibiotics on the elimination of Agrobacterium and high frequency Agrobacterium-mediated transformation of indica rice (Oryza sativa L.). Czech J. Genet. Plant Breed. 2012, 48, 120–130. [Google Scholar] [CrossRef]
- Grzebelus, E.; Skop, L. Effect of β-lactam antibiotics on plant regeneration in carrot protoplast cultures. In Vitro Cell. Dev. Biol. Plant 2014, 50, 568–575. [Google Scholar] [CrossRef]
- Qin, Y.H.; Teixeira da Silva, J.A.; Bi, J.H.; Zhang, S.L.; Hu, G.B. Response of in vitro strawberry to antibiotics. Plant Growth Regul. 2011, 65, 183–193. [Google Scholar] [CrossRef]
- Cheng, Z.M.; Schnurr, J.A.; Kapaun, J.A. Timentin as an alternative antibiotic for suppression of Agrobacterium tumefaciens in genetic transformation. Plant Cell Rep. 1998, 17, 646–649. [Google Scholar] [CrossRef]
- Kumar, R.; Mamrutha, H.M.; Kaur, A.; Grewal, A. Synergistic effect of cefotaxime and timentin to suppress the Agrobacterium overgrowth in wheat (Triticum aestivum L.) transformation. Asian J. Microbiol., Biotechnol. Environ. Sci. 2017, 19, 961–967. [Google Scholar]
- Topping, J.F.; Lindsey, K. Shoot Cultures and Root Cultures Of Tobacco. In Plant Tissue Culture Manual; Lindsey, K., Ed.; Springer: Dordrecht, The Netherlands, 1991; pp. 67–79. [Google Scholar]
- Colgan, R.; Atkinson, C.J.; Paul, M.; Hassan, S.; Drake, P.M.W.; Sexton, A.L.; Santa-Cruz, S.; James, D.; Hamp, K.; Gutteridge, C.; et al. Optimisation of contained Nicotiana tabacum cultivation for the production of recombinant protein pharmaceuticals. Transgenic Res. 2010, 19, 241–256. [Google Scholar] [CrossRef]
- Tremblay, R.; Wang, D.; Jevnikar, A.M.; Ma, S. Tobacco, a highly efficient green bioreactor for production of therapeutic proteins. Biotechnol. Adv. 2010, 28, 214–221. [Google Scholar] [CrossRef]
- Moustafa, K.; Makhzoum, A.; Tremouillaux-Guiller, J. Molecular farming on rescue of pharma industry for next generations. Crit. Rev. Biotechnol. 2016, 36, 840–850. [Google Scholar] [CrossRef]
- Zhou, J.; Yu, L.; Zhang, J.; Zhang, X.; Xue, Y.; Liu, J.; Zou, X. Characterization of the core microbiome in tobacco leaves during aging. Microbiologyopen 2020, 9, e984. [Google Scholar] [CrossRef]
- Chen, X.; Krug, L.; Yang, H.; Li, H.; Yang, M.; Berg, G.; Cernava, T. Nicotiana tabacum seed endophytic communities share a common core structure and genotype-specific signatures in diverging cultivars. Comput. Struct. Biotechnol. J. 2020, 18, 287–295. [Google Scholar] [CrossRef]
- Chen, Z.; Huang, L.; Xia, Z.; Zhao, X.; Xu, S.; Lin, L.; Ren, Z.; Jin, S.; Wang, M. Species diversity characteristics of endophytic bacteria in tobacco at different regions of Yunnan Province. Southwest China J. Agric. Sci. 2015, 28, 857–861. [Google Scholar]
- Doyle, J. DNA Protocols for Plants. In Molecular Techniques in Taxonomy; Hewitt, G.M., Johnston, A.W.B., Young, J.P.W., Eds.; Springer: Berlin/Heidelberg, Germany, 1991; pp. 283–293. [Google Scholar]
- Ding, T.; Palmer, M.W.; Melcher, U. Community terminal restriction fragment length polymorphisms reveal insights into the diversity and dynamics of leaf endophytic bacteria. BMC Microbiol. 2013, 13, 1. [Google Scholar] [CrossRef]
- Li, H.; Luo, J.; Hemphill, J.K.; Wang, J.-T.; Gould, J.H. A rapid and high yielding DNA miniprep for cotton (Gossypium spp.). Plant Mol. Biol. Rep. 2001, 19, 183. [Google Scholar] [CrossRef]
- Wang, H.X.; Geng, Z.L.; Zeng, Y.; Shen, Y.M. Enriching plant microbiota for a metagenomic library construction. Environ. Microbiol. 2008, 10, 2684–2691. [Google Scholar] [CrossRef]
- Aloisio, I.; Quagliariello, A.; De Fanti, S.; Luiselli, D.; De Filippo, C.; Albanese, D.; Corvaglia, L.T.; Faldella, G.; Di Gioia, D. Evaluation of the effects of intrapartum antibiotic prophylaxis on newborn intestinal microbiota using a sequencing approach targeted to multi hypervariable 16S rDNA regions. Appl. Microbiol. Biotechnol. 2016, 100, 5537–5546. [Google Scholar] [CrossRef]
- Winand, R.; Bogaerts, B.; Hoffman, S.; Lefevre, L.; Delvoye, M.; Van Braekel, J.; Fu, Q.; Roosens, N.H.; De Keersmaecker, S.C.; Vanneste, K. Targeting the 16S rRNA gene for bacterial identification in complex mixed samples: Comparative evaluation of second (illumina) and third (oxford nanopore technologies) generation sequencing technologies. Int. J. Mol. Sci. 2020, 21, 298. [Google Scholar] [CrossRef]
- Torrell, H.; Cereto-Massagué, A.; Kazakova, P.; García, L.; Palacios, H.; Canela, N. Multiomic approach to analyze infant gut microbiota: Experimental and analytical method optimization. Biomolecules 2021, 11, 999. [Google Scholar] [CrossRef]
- Erlacher, A.; Cernava, T.; Cardinale, M.; Soh, J.; Sensen, C.W.; Grube, M.; Berg, G. Rhizobiales as functional and endosymbiontic members in the lichen symbiosis of Lobaria pulmonaria L. Front. Microbiol. 2015, 6, 53. [Google Scholar] [CrossRef]
- Abraham, W.-R.; Rohde, M.; Bennasar, A. The Family Caulobacteraceae. In The Prokaryotes: Alphaproteobacteria and Betaproteobacteria; Rosenberg, E., DeLong, E.F., Lory, S., Stackebrandt, E., Thompson, F., Eds.; Springer: Berlin/Heidelberg, Germany, 2014; pp. 179–205. [Google Scholar]
- Glaeser, S.P.; Kämpfer, P. The Family Sphingomonadaceae. In The Prokaryotes: Alphaproteobacteria and Betaproteobacteria; Rosenberg, E., DeLong, E.F., Lory, S., Stackebrandt, E., Thompson, F., Eds.; Springer: Berlin/Heidelberg, Germany, 2014; pp. 641–707. [Google Scholar]
- Velusamy, K.; Krishnani, K.K. Heterotrophic nitrifying and oxygen tolerant denitrifying bacteria from greenwater system of coastal aquaculture. Appl. Biochem. Biotechnol. 2013, 169, 1978–1992. [Google Scholar] [CrossRef]
- Doronina, N.; Kaparullina, E.; Trotsenko, Y. The Family Methylophilaceae. In The Prokaryotes: Alphaproteobacteria and Betaproteobacteria; Rosenberg, E., DeLong, E.F., Lory, S., Stackebrandt, E., Thompson, F., Eds.; Springer: Berlin/Heidelberg, Germany, 2014; pp. 869–880. [Google Scholar]
- Torres, A.R.; Araujo, W.L.; Cursino, L.; Hungria, M.; Plotegher, F.; Mostasso, F.L.; Azevedo, J.L. Diversity of endophytic enterobacteria associated with different host plants. J. Microbiol. 2008, 46, 373–379. [Google Scholar] [CrossRef]
- Bünger, W.; Jiang, X.; Müller, J.; Hurek, T.; Reinhold-Hurek, B. Novel cultivated endophytic Verrucomicrobia reveal deep-rooting traits of bacteria to associate with plants. Sci. Rep. 2020, 10, 8692. [Google Scholar] [CrossRef]
- Turenne, C.Y.; Tschetter, L.; Wolfe, J.; Kabani, A. Necessity of quality-controlled 16S rRNA gene sequence databases: Identifying nontuberculous Mycobacterium species. J. Clin. Microbiol. 2001, 39, 3637–3648. [Google Scholar] [CrossRef]
- Milani, C.; Hevia, A.; Foroni, E.; Duranti, S.; Turroni, F.; Lugli, G.A.; Sanchez, B.; Martín, R.; Gueimonde, M.; van Sinderen, D.; et al. Assessing the fecal microbiota: An optimized ion torrent 16S rRNA gene-based analysis protocol. PLoS ONE 2013, 8, e68739. [Google Scholar] [CrossRef]
- Cai, L.; Ye, L.; Tong, A.H.Y.; Lok, S.; Zhang, T. Biased diversity metrics revealed by bacterial 16S pyrotags derived from different primer sets. PLoS ONE 2013, 8, e53649. [Google Scholar] [CrossRef]
- Thomas, P.; Sekhar, A.C.; Shaik, S.P. High taxonomic diversity of cultivation-recalcitrant endophytic bacteria in grapevine field shoots, their in vitro introduction, and unsuspected persistence. Planta 2017, 246, 879–898. [Google Scholar] [CrossRef] [PubMed]
- Johnston-Monje, D.; Raizada, M.N. Conservation and diversity of seed associated endophytes in Zea across boundaries of evolution, ethnography and ecology. PLoS ONE 2011, 6, e20396. [Google Scholar] [CrossRef] [PubMed]
- Shahzad, R.; Khan, A.L.; Bilal, S.; Asaf, S.; Lee, I.J. What is there in seeds? Vertically transmitted endophytic resources for sustainable improvement in plant growth. Front. Plant Sci. 2018, 9, 24. [Google Scholar] [CrossRef] [PubMed]
- Fedrizzi, T.; Meehan, C.J.; Grottola, A.; Giacobazzi, E.; Fregni Serpini, G.; Tagliazucchi, S.; Fabio, A.; Bettua, C.; Bertorelli, R.; De Sanctis, V.; et al. Genomic characterization of Nontuberculous Mycobacteria. Sci. Rep. 2017, 7, 45258. [Google Scholar] [CrossRef]
- Leff, J.W.; Lynch, R.C.; Kane, N.C.; Fierer, N. Plant domestication and the assembly of bacterial and fungal communities associated with strains of the common sunflower, Helianthus annuus. New Phytol. 2017, 214, 412–423. [Google Scholar] [CrossRef]
- Wang, W.F.; Zhai, Y.Y.; Cao, L.X.; Tan, H.M.; Zhang, R.D. Illumina-based analysis of core actinobacteriome in roots, stems, and grains of rice. Microbiol. Res. 2016, 190, 12–18. [Google Scholar] [CrossRef]
- De Vries, H.J.; Beyer, F.; Jarzembowska, M.; Lipińska, J.; van den Brink, P.; Zwijnenburg, A.; Timmers, P.H.A.; Stams, A.J.M.; Plugge, C.M. Isolation and characterization of Sphingomonadaceae from fouled membranes. Npj Biofilm. Microbio. 2019, 5, 6. [Google Scholar] [CrossRef]
- Walsh, C.M.; Gebert, M.J.; Delgado-Baquerizo, M.; Maestre, F.T.; Fierer, N. A global survey of Mycobacterial diversity in soil. Appl. Environ. Microbiol. 2019, 85, e01180-19. [Google Scholar] [CrossRef]
- Bouam, A.; Armstrong, N.; Levasseur, A.; Drancourt, M. Mycobacterium terramassiliense, Mycobacterium rhizamassiliense and Mycobacterium numidiamassiliense sp. nov., three new Mycobacterium simiae complex species cultured from plant roots. Sci. Rep. 2018, 8, 9309. [Google Scholar] [CrossRef]
- Mano, H.; Tanaka, F.; Nakamura, C.; Kaga, H.; Morisaki, H. Culturable endophytic bacterial flora of the maturing leaves and roots of rice plants (Oryza sativa) cultivated in a paddy field. Microbes Environ. 2007, 22, 175–185. [Google Scholar] [CrossRef]
- Conn, V.M.; Franco, C.M.M. Analysis of the endophytic actinobacterial population in the roots of wheat (Triticum aestivum L.) by terminal restriction fragment length polymorphism and sequencing of 16S rRNA clones. Appl. Environ. Microbiol. 2004, 70, 1787–1794. [Google Scholar] [CrossRef] [PubMed]
- Koskimäki, J.J.; Hankala, E.; Suorsa, M.; Nylund, S.; Pirttilä, A.M. Mycobacteria are hidden endophytes in the shoots of rock plant [Pogonatherum paniceum (Lam.) Hack.] (Poaceae). Environ. Microbiol. Rep. 2010, 2, 619–624. [Google Scholar] [CrossRef] [PubMed]
- Pirttilä, A.M.; Pospiech, H.; Laukkanen, H.; Myllylä, R.; Hohtola, A. Seasonal variations in location and population structure of endophytes in buds of Scots pine. Tree Physiol. 2005, 25, 289–297. [Google Scholar] [CrossRef] [PubMed]
- Pan, L.J.; Chen, J.M.; Ren, S.M.; Shen, H.G.; Rong, B.; Liu, W.; Yang, Z.M. Complete genome sequence of Mycobacterium Mya-zh01, an endophytic bacterium, promotes plant growth and seed germination isolated from flower stalk of Doritaenopsis. Arch. Microbiol. 2020, 202, 1965–1976. [Google Scholar] [CrossRef]
- Tsavkelova, E.A.; Cherdyntseva, T.A.; Netrusov, A.I. Bacteria associated with the roots of epiphytic orchids. Microbiology 2004, 73, 710–715. [Google Scholar] [CrossRef]
- Tsavkelova, E.A.; Egorova, M.A.; Leontieva, M.R.; Malakho, S.G.; Kolomeitseva, G.L.; Netrusov, A.I. Dendrobium nobile Lindl. seed germination in co- cultures with diverse associated bacteria. Plant Growth Regul. 2016, 80, 79–91. [Google Scholar] [CrossRef]
- Kazda, J. Mycobacteria as habitat microorganisms of sphagnum bog vegetation. In The Ecology of Mycobacteria; Kazda, J., Ed.; Springer: Dordrecht, The Netherlands, 2000; pp. 32–36. [Google Scholar]
- Kazda, J.; Stackebrandt, E.; Smida, J.; Minnikin, D.E.; Daffe, M.; Parlett, J.H.; Pitulle, C. Mycobacterium cookii sp. nov. Int. J. Syst. Bacteriol. 1990, 40, 217–223. [Google Scholar] [CrossRef]
- Quambusch, M.; Pirttilä, A.M.; Tejesvi, M.V.; Winkelmann, T.; Bartsch, M. Endophytic bacteria in plant tissue culture: Differences between easy- and difficult-to-propagate Prunus avium genotypes. Tree Physiol. 2014, 34, 524–533. [Google Scholar] [CrossRef]
- Laukkanen, H.; Soini, H.; Kontunen-Soppela, S.; Hohtola, A.; Viljanen, M. A mycobacterium isolated from tissue cultures of mature Pinus sylvestris interferes with growth of Scots pine seedlings. Tree Physiol. 2000, 20, 915–920. [Google Scholar] [CrossRef][Green Version]
- Zheng, J.Y.; Zhang, J.X.; Gao, L.; Kong, F.Y.; Shen, G.M.; Wang, R.; Gao, J.M.; Zhang, J.G. The effects of tetracycline residues on the microbial community structure of tobacco soil in pot experiment. Sci. Rep. 2020, 10, 8804. [Google Scholar] [CrossRef]
- Fatahi-Bafghi, M. Antibiotic resistance genes in the Actinobacteria phylum. Eur. J. Clin. Microbiol. Infect. Dis. 2019, 38, 1599–1624. [Google Scholar] [CrossRef]
- Chaïbi, E.B.; Sirot, D.; Paul, G.; Labia, R. Inhibitor-resistant TEM β-lactamases: Phenotypic, genetic and biochemical characteristics. J. Antimicrob. Chemother. 1999, 43, 447–458. [Google Scholar] [CrossRef]
- Berg, G.; Koberl, M.; Rybakova, D.; Muller, H.; Grosch, R.; Smalla, K. Plant microbial diversity is suggested as the key to future biocontrol and health trends. FEMS Microbiol. Ecol. 2017, 93, fix050. [Google Scholar] [CrossRef]
- Sessitsch, A.; Mitter, B. 21st century agriculture: Integration of plant microbiomes for improved crop production and food security. Microb. Biotechnol. 2015, 8, 32–33. [Google Scholar] [CrossRef]
- Murashige, T.; Skoog, F. A revised medium for rapid growth and bio assays with tobacco tissue cultures. Physiol. Plant. 1962, 15, 473–497. [Google Scholar] [CrossRef]
- Hodges, D.M.; DeLong, J.M.; Forney, C.F.; Prange, R.K. Improving the thiobarbituric acid-reactive-substances assay for estimating lipid peroxidation in plant tissues containing anthocyanin and other interfering compounds. Planta 1999, 207, 604–611. [Google Scholar] [CrossRef]
- Jagendorf, A.T.; Takabe, T. Inducers of glycinebetaine synthesis in barley. Plant Physiol. 2001, 127, 1827–1835. [Google Scholar] [CrossRef]
- Li, J.H.; Wang, E.T.; Chen, W.F.; Chen, W.X. Genetic diversity and potential for promotion of plant growth detected in nodule endophytic bacteria of soybean grown in Heilongjiang province of China. Soil Biol. Biochem. 2008, 40, 238–246. [Google Scholar] [CrossRef]
- Akinsanya, M.A.; Goh, J.K.; Lim, S.P.; Ting, A.S.Y. Metagenomics study of endophytic bacteria in Aloe vera using next-generation technology. Genom. Data 2015, 6, 159–163. [Google Scholar] [CrossRef]
- Tamošiūnė, I.; Gelvonauskienė, D.; Haimi, P.; Mildažienė, V.; Koga, K.; Shiratani, M.; Baniulis, D. Cold plasma treatment of sunflower seeds modulates plant-associated microbiome and stimulates root and lateral organ growth. Front. Plant Sci. 2020, 11, 568924. [Google Scholar] [CrossRef]
- Madden, T.L.; Tatusov, R.L.; Zhang, J. Applications of network BLAST server. Methods Enzymol. 1996, 266, 131–141. [Google Scholar] [CrossRef]
- Chong, J.; Liu, P.; Zhou, G.Y.; Xia, J.G. Using MicrobiomeAnalyst for comprehensive statistical, functional, and meta-analysis of microbiome data. Nat. Protoc. 2020, 15, 799–821. [Google Scholar] [CrossRef]
- Zakrzewski, M.; Proietti, C.; Ellis, J.J.; Hasan, S.; Brion, M.-J.; Berger, B.; Krause, L. Calypso: A user-friendly web-server for mining and visualizing microbiome-environment interactions. Bioinformatics 2017, 33, 782–783. [Google Scholar] [CrossRef]
- Lex, A.; Gehlenborg, N.; Strobelt, H.; Vuillemot, R.; Pfister, H. UpSet: Visualization of intersecting sets. IEEE Trans. Vis. Comput. Graph. 2014, 20, 1983–1992. [Google Scholar] [CrossRef]

Publisher’s Note: MDPI stays neutral with regard to jurisdictional claims in published maps and institutional affiliations. |
© 2022 by the authors. Licensee MDPI, Basel, Switzerland. This article is an open access article distributed under the terms and conditions of the Creative Commons Attribution (CC BY) license (https://creativecommons.org/licenses/by/4.0/).
Share and Cite
Tamošiūnė, I.; Andriūnaitė, E.; Vinskienė, J.; Stanys, V.; Rugienius, R.; Baniulis, D. Enduring Effect of Antibiotic Timentin Treatment on Tobacco In Vitro Shoot Growth and Microbiome Diversity. Plants 2022, 11, 832. https://doi.org/10.3390/plants11060832
Tamošiūnė I, Andriūnaitė E, Vinskienė J, Stanys V, Rugienius R, Baniulis D. Enduring Effect of Antibiotic Timentin Treatment on Tobacco In Vitro Shoot Growth and Microbiome Diversity. Plants. 2022; 11(6):832. https://doi.org/10.3390/plants11060832
Chicago/Turabian StyleTamošiūnė, Inga, Elena Andriūnaitė, Jurgita Vinskienė, Vidmantas Stanys, Rytis Rugienius, and Danas Baniulis. 2022. "Enduring Effect of Antibiotic Timentin Treatment on Tobacco In Vitro Shoot Growth and Microbiome Diversity" Plants 11, no. 6: 832. https://doi.org/10.3390/plants11060832
APA StyleTamošiūnė, I., Andriūnaitė, E., Vinskienė, J., Stanys, V., Rugienius, R., & Baniulis, D. (2022). Enduring Effect of Antibiotic Timentin Treatment on Tobacco In Vitro Shoot Growth and Microbiome Diversity. Plants, 11(6), 832. https://doi.org/10.3390/plants11060832

